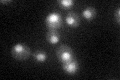
YNR024W
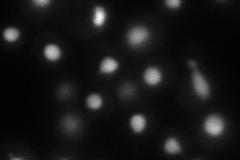
YNR024W
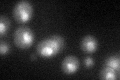
YNR024W
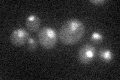
YNR024W

View description
Nuclear exosome-associated RNA binding protein; involved in surveillance of pre-rRNAs and pre-mRNAs, and the degradation of cryptic non-coding RNAs (ncRNA); copurifies with ribosomes
Localization:
Intensity:
Fold change:
Significance:
-
C’ GFP library in SD
nucleus29.18 -
N' NOP1pr-GFP in SD
nucleus95.1152 -
N' TEF2pr-mCherry in SD

nucleus24.865 -
N' NATIVEpr-GFP in SD

nucleus35.7568 -
N' TEF2pr-VC and Cyto-VN in SD

nucleus42.6347 -
C’ GFP library in SD+DTT
nucleus21.890.75No -
C’ GFP library in SD+H2O2

nucleus27.460.94No -
C’ GFP library in Starvation Media
nucleus24.420.83No -
C’ GFP library on the background of Pup2-DaMP

nucleus -
C’ GFP library on the background of CCT mutant

nucleus29.75231.01944No
